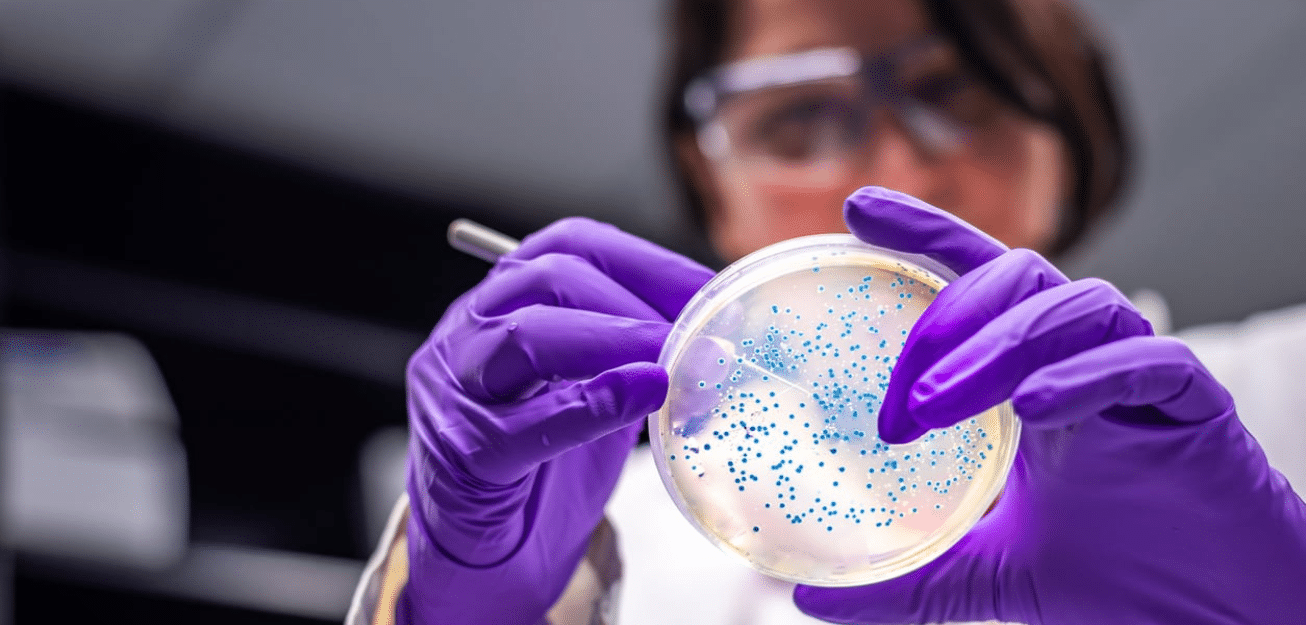
The Five Medical Specialties Most Impacted by Doctor Shortages_sq

At Tiber Health, we’re working to help address one of the most pressing problems facing the healthcare industry: the shortage of doctors. According to the most recent workforce projections by the American Association of Medical Colleges (AAMC), the United States could face a shortage of up to 86,000 physicians by 2036.
These shortages, however, won’t be evenly distributed. Some specialties face deeper deficits than others. Factors driving these shortages vary and can include a higher proportion of specialists near retirement, longer training times, location, and more. This article looks at five medical specialties likely to experience the most severe physician shortages in the coming decades.
Vascular Surgery
Vascular surgeons manage complex conditions involving arteries and veins, including aneurysms, peripheral artery disease, and dialysis access. Recent projections from the U.S. Health Resources and Services Administration (HRSA) predict that by 2037, there will only be enough vascular surgeons to meet 64% of healthcare demands – the lowest supply-to-demand ratio of all specialties.
The training path is long and highly specialized, and fewer residency and fellowship slots exist compared to demand. Additionally, an unusually large portion of the current vascular surgery workforce is nearing retirement – in a 2022 address to the Society for Vascular Surgery, Dr. Michel Makaroun noted that while 32% of all physicians in the U.S. were 55 and older, 42% of vascular surgeons were in that age bracket.
A shortage of vascular surgeons could result in:
- Limited access to life-saving procedures in urgent situations
- Increased limb amputations from untreated peripheral artery disease
- Delays in elective procedures like endovascular repairs
The shortage of vascular surgeons is particularly dire in rural and underserved areas, where patients often face long travel times and worse outcomes due to delays in care.
Thoracic Surgery
Thoracic surgeons operate on the lungs, esophagus, and other organs in the chest. Training takes over a decade, and the specialty faces a dual challenge: high burnout due to the demanding nature of the work and a rapidly aging patient population requiring more surgeries. For example, a 2024 paper in the Journal of Thoracic and Cardiovascular surgery found that the number of cardiothoracic surgeons per 100,000 people in the U.S. declined by 12 per cent, and linked this decline to poorer outcomes for lung cancer patients in particular.
A thoracic surgery shortage could lead to:
- Delays in lung cancer resections and other time-sensitive surgeries
- Strain on existing surgical teams in academic and community hospitals
- Lack of availability to life-saving surgery in smaller and rural hospitals
The Society of Thoracic Surgeons estimates that 900 cardiothoracic surgeons will retire by 2035, during which time demand will rise by 20 per cent. This would mean that there would only be enough thoracic surgeons to cover 69 per cent of demand for procedures.
Ophthalmology
Ophthalmologists manage everything from cataracts and glaucoma to retinal diseases and eye trauma. With an aging population experiencing higher rates of vision problems, the demand for eye care is outpacing the number of new ophthalmologists entering the field. The HRSA projects that there will only be enough ophthalmologists to meet 68% of demand by 2037.
This might result in:
- Long waits for vision-restoring surgeries like cataract removal
- Delayed diagnosis and treatment of conditions like macular degeneration
- Reduced access in rural or lower-income areas
Over one-third of practicing ophthalmologists are over age 60, and retirements are expected to significantly outpace new graduates in the coming years. In fact, a 2022 article in the Review of Ophthalmology reported that while 550 ophthalmologists were expected to retire each year over the next decade, only 450 new doctors are graduating from residency programs. In the meantime, demand for eye care is projected to rise by 5 per cent per year.
Family Medicine
Family medicine physicians are the cornerstone of primary care, especially in rural and underserved communities. Yet the specialty has struggled to compete with higher-paying and more specialized fields. Many graduates from U.S. medical schools are opting for other paths, while family medicine residency slots go increasingly to international graduates.
A lack of primary care physicians, including family physicians, can mean:
- Delays to or gaps in preventive care and chronic disease management
- Rising use of urgent care and ERs for non-emergent issues
- Physician burnout from high patient volume and administrative burdens
HRSA projections indicate that by 2037, we will only have 73 per cent of the family physicians required to meet care needs.
Geriatrics
Despite the growing population of Americans over 60, geriatrics remains one of the most underrepresented fields in medicine. The specialty tends to attract fewer trainees due to lower compensation and limited visibility in medical education. Geriatricians are uniquely trained to manage the complexities of aging, including dementia, frailty, and polypharmacy.
Without enough geriatricians to care for senior citizens, we could face:
- Poor care coordination for elderly patients with multiple conditions
- Increased hospitalizations and emergency visits due to unmanaged issues
- Heavier reliance on generalists without geriatric-specific expertise
The American Geriatrics Society reports that there are fewer than 7,000 board-certified geriatricians are practicing in the U.S., despite tens of millions of Americans entering their senior years. HRSA projections indicate that by 2037, there will only be enough geriatricians to cover 78 per cent of healthcare needs in this specialty.
Contributing to a Solution to Physician Shortages – in Any Specialty
From complex surgeries to basic primary care, the consequences of physician shortages are far-reaching — delayed diagnoses, worse outcomes, and increased strain on remaining providers. Addressing these shortages requires a multi-layered approach: expanding residency and fellowship opportunities, creating incentives for rural practice, reducing administrative burdens, and investing in workforce development programs.
Your institution can play a role in alleviating these shortages by partnering with Tiber Health to offer a Master of Science in Medical Sciences. This innovative pipeline program combines an LCME-accredited medical curriculum with a predictive analytics-powered learning environment that helps talented students develop the skills and confidence they need to successfully apply to medical school. Learn more here.